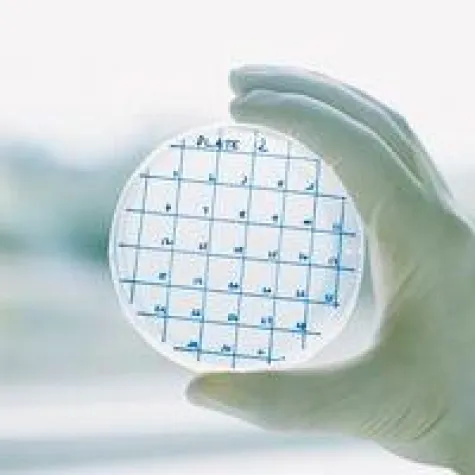
Bild: In Berlin - „Zukunftskonferenz Biotechnologie“

(openPR) Spezielle Enzyme im Waschmittel, besondere Impfstoffe und innovative Methoden für die Pflanzenzüchtung: Die Einsatzmöglichkeiten der Biotechnologie – in den Sektoren Landwirtschaft, Gesundheitswirtschaft und Industrie – sind noch lange nicht erschöpft. Künftige Herausforderungen können mit dieser Technologie bewältigt werden, die auch aus diesem Grund als Zukunftsfeld bezeichnet wird. Ihre Potenziale und Chancen stehen daher bei der „Zukunftskonferenz Biotechnologie“ am 5. Mai 2009 in Berlin im Mittelpunkt. Experten aus Wissenschaft, Politik und Wirtschaft diskutieren dann die Bedeutung der Biotechnologie für Ostdeutschland.
Unter dem Motto „Biotechnologie - Bausteine des Lebens“ ist das Ziel der Zukunftskonferenz, die ostdeutschen Potenziale in biotechnologischen Einsatzfeldern aufzuzeigen. Denn in den neuen Bundesländern gilt diese Technologie als ein zentraler Schlüssel für die weitere wirtschaftliche Entwicklung. Maßgeblich für ihren bisherigen Erfolg in Ostdeutschland ist die enge Verzahnung von Wissenschaft und Wirtschaft. Diese Basis erlaubt das schnelle Überführen wissenschaftlicher Erkenntnisse in die wirtschaftliche Anwendung und folglich die produktive Nutzung. Bei der Konferenz sollen Wege erarbeitet werden, wie diese Potenziale so weiterentwickelt werden können, dass die neuen Länder bei der Erforschung und Anwendung der Biotechnologie internationales Spitzenniveau erreichen können. Auch die Frage, welchen Beitrag das Zukunftsfeld Biotechnologie für die weitere wirtschaftliche Entwicklung Ostdeutschlands leisten kann, gilt es zu diskutieren.
Wolfgang Tiefensee, Bundesminister für Verkehr, Bau und Stadtentwicklung sowie Beauftragter der Bundesregierung für die neuen Bundesländer, wird einen Überblick über bisher Geleistetes und künftige Ansätze geben. Professor Dr. Stefan Hell vom Göttinger Max-Planck-Institut für biophysikalische Chemie zeigt neue experimentelle Möglichkeiten in der Biotechnologie unter dem Motto „Grenzenlos scharf - Lichtmikroskopie für die Biotechnologie des 21. Jahrhunderts“ auf. Den Status Quo und Entwicklungsperspektiven präsentiert Dr. Axel Zweck, Leiter von Zukünftige Technologien Consulting der VDI Technologiezentrum GmbH. Vorgestellt werden Erfolgsgeschichten aus den neuen Bundesländern, die durch zwei Diskussionsrunden zu den Themen „Innovative Anwendungsfelder und Kommerzialisierungsstrategien“ sowie „Herausforderungen für Ostdeutschland im Zukunftsfeld Biotechnologie“ ergänzt werden.
Eingebettet ist die Veranstaltung in die Konferenzreihe „Zukunftsfelder in Ostdeutschland“, die 2008 von Wolfgang Tiefensee ins Leben gerufen wurde. In diesem Rahmen wird über neue und innovative Entwicklungen in Wirtschaft, Gesellschaft und Forschung informiert und diskutiert. Inhaltlich vorbereitet wird die „Zukunftskonferenz Biotechnologie“ von der VDI Technologienzentrum GmbH, die auch die Aufbereitung einer an das Themenfeld gekoppelte Studie durchführt. Erste Ergebnisse der Studie „Chancen der Biotechnologie für Ostdeutschland“ werden bei der Konferenz veröffentlicht.